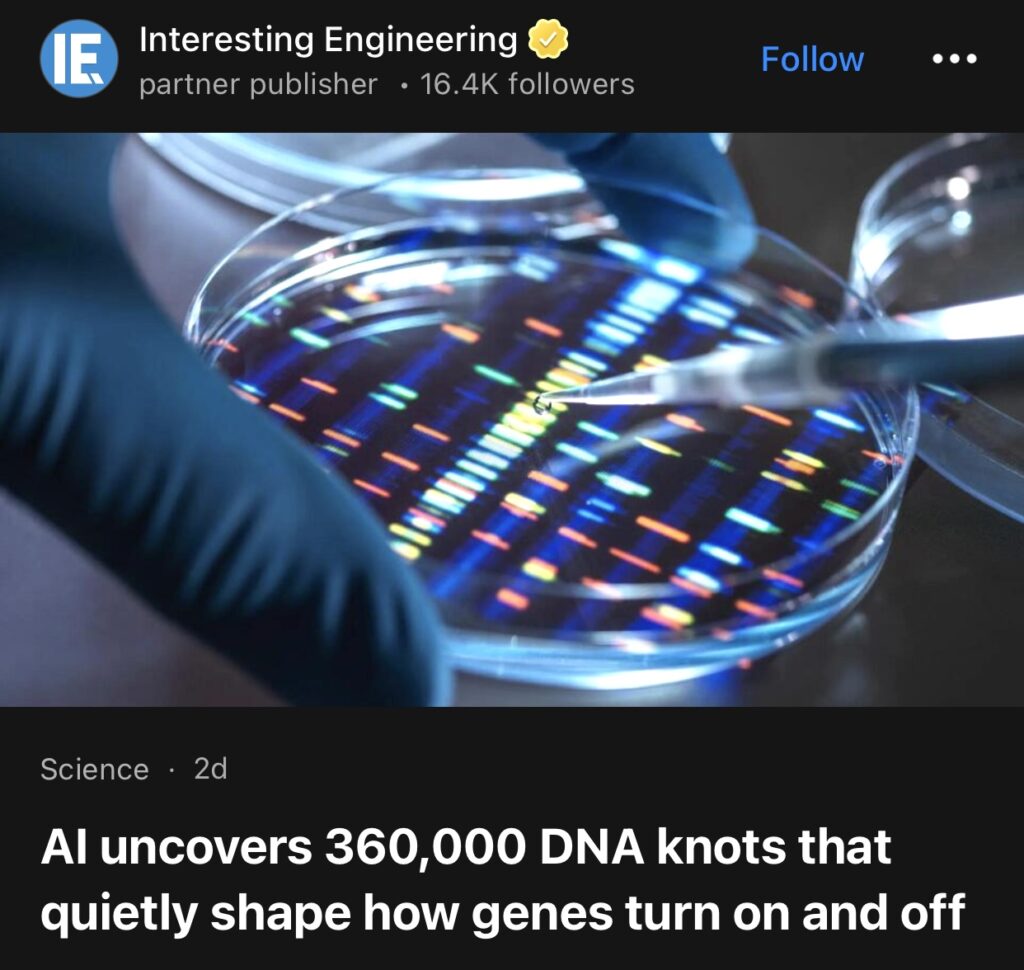

1。莫斯科,12月26日(路透社)——克里姆林宫周五表示,俄罗斯总统弗拉基米尔·普京的外交政策顾问在莫斯科收到美国关于可能达成的乌克兰和平协议的提议后,与美国政府成员进行了交谈。

2。据Interesting Engineering报道,人工智能发现36万个DNA结,这些DNA结悄然影响着基因的开启和关闭。
3。据Daily Mail报道,泽连斯基表示,如果俄罗斯同意60天停火,他将就特朗普的和平计划举行全民公投。

4。据Earth.com报道,加拿大发现几乎取之不尽的锂矿储量。

5。据Interesting Engineering报道,世界最长的高速公路隧道在中国开通,海拔9842英尺。

6。据Interesting Engineering报道,日本科学家通过捕获更长波长的太阳光来提高太阳能制氢产量。

7。据CNN报道,特朗普承诺明年推行“积极的”住房改革。许多经济学家对明年的房地产市场持乐观态度。他们预计,收入增长速度将超过房价上涨速度,使许多美国人觉得住房更加负担得起。

8。据Express U.S.报道,中国军舰和飞机夜间进入台湾周边水域和空域。

9。据Altitude Post报道,胡塞武装领导人警告称,未来与以色列的冲突“不可避免”。

10。北京,12月27日(路透社)——由于国内需求疲软抵消了出口的韧性,中国工业企业11月份利润以一年多来最快的速度下降,这再次表明经济复苏步履蹒跚,也支持了要求出台更多政策刺激措施的呼声。

11。12月24日(路透社)——以色列总理本雅明·内塔尼亚胡周三表示,一名军官在加沙地带被爆炸炸伤后,以色列将进行报复。哈马斯否认对此负责,并暗示爆炸装置是冲突遗留下来的。

12。日本内阁周五批准了一项创纪录的国防预算计划,金额超过9万亿日元(580亿美元),旨在加强其反击能力和海岸防御,为此将部署巡航导弹和无人武器库,以应对地区紧张局势的加剧。

13。据The US Sun报道,在特朗普和泽连斯基关键和平峰会召开前一天,普京对基辅发动猛烈攻击,这位独裁者对乌克兰首都进行轰炸。

14。据Express U.S.报道,停火失败后,紧张局势升级,泰国战机向柬埔寨投掷了40枚炸弹。

15。北京,12月27日(路透社)——中国周六通过了一项关键立法的修订案,旨在加强北京发动贸易战的能力,限制从战略矿产到性玩偶等商品的出口,并进一步开放其19万亿美元的经济。

以下为华人服务广告区:




如果大家喜欢“简报”,希望登陆网站americannewsdigest24.com, 点击小铃铛订阅,每月仅$2美元。有你们的支持我会把“简报”办得更好。谢谢!
顾震帝 2025年,12月28日于美国康州。

Best Turkey tours Mia K. ★★★★★ Pottery workshop with Master Ahmet – he made clay dance! Shipped my creations home safely. Highlight of Turkey! https://salud-postural.com/?p=2212
custom Turkey tours Jennifer C. – İrlanda https://ordinet.in/?p=7104
Wonderful web site Lots of useful info here Im sending it to a few friends ans additionally sharing in delicious And obviously thanks to your effort
Turkey food tours Grace R. – İran https://ceritabanten.com?p=920
Mediterranean tours Turkey Outstanding Turkey tours packed with history! Ancient trade route connections were fascinating. https://jananiarchitects.com/?p=1639
Turkey travel packages Amazing Turkey tours! The night life in Istanbul and beach clubs in Bodrum were incredible experiences. https://evolvff.com/?p=3712